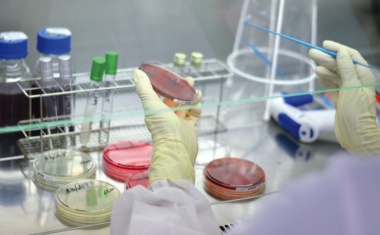
Photo

Kundenorientierung durch Prozessautomatisierung
Moderne Logistiklösungen sind durch Prozessautomatisierung und einen starken Fokus auf Kundenbedürfnisse geprägt. Als Experte im Bereich Gefahrstofflagerung bietet Infraserv Logistics (ISL) ein hochflexibles System, das sich durch Effizienz und höchste Sicherheit auszeichnet.